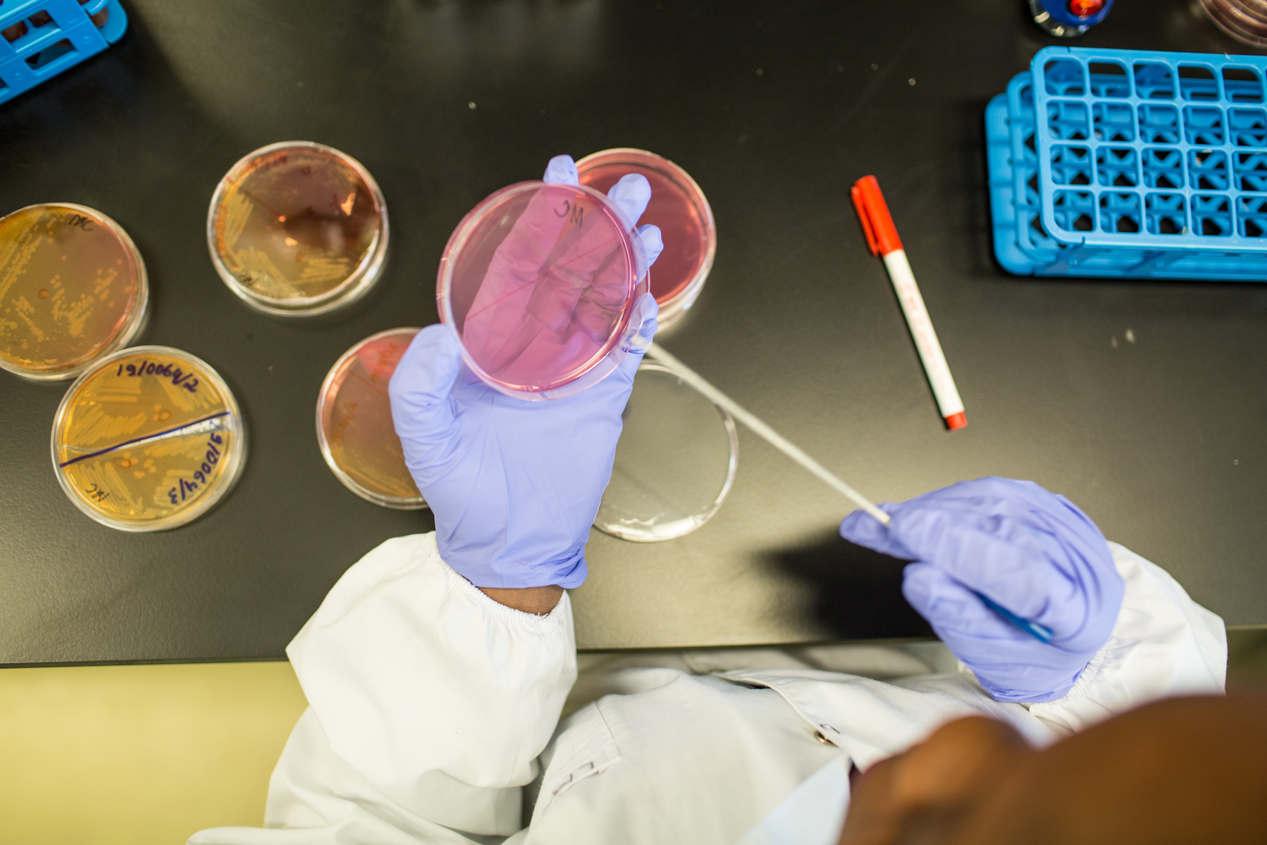

#Fica Atento
O que é?
O Fica Atento é a Plataforma de Informação e Observação da Resposta a Emergências de Saúde Pública, concebida com o propósito de agregar informação de acesso rápido, incluindo dados epidemiológicos, conteúdos de carácter noticioso e outros materiais de relevante interesse público.
O Fica Atento tem como objectivos:
• Disponibilizar informação actualizada e de acesso rápido sobre emergências de saúde pública, incluindo dados epidemiológicos relevantes para a tomada de decisão;
• Reforçar a vigilância e a observação da resposta a emergências de saúde pública, através da sistematização e divulgação de informação estratégica;
• Promover a comunicação pública e institucional por meio da disseminação de conteúdos noticiosos fiáveis e validados sobre eventos de saúde pública;
• Contribuir para o aumento da literacia em saúde e do envolvimento do público, disponibilizando conteúdos de interesse público que apoiem a prevenção, a preparação e a resposta a emergências.